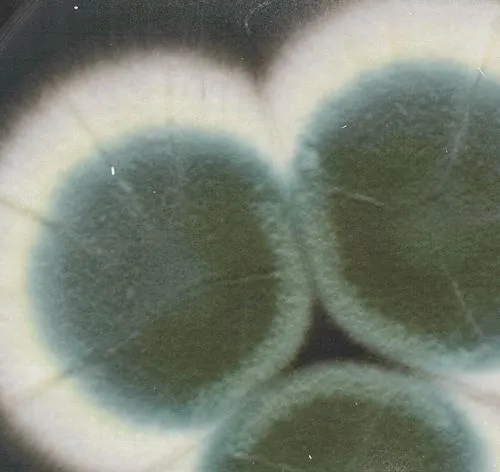

Male Partner BV Treatment
7-day regimen of oral metronidazole and topical clindamycin
A science-backed antibiotic regimen for men designed to help your female partner break the cycle of BV.
Recurrent BV can be incredibly frustrating—but emerging research suggests that treating male partners for BV-associated bacteria may reduce the risk of recurrence in their female partners.
If prescribed, this treatment combines oral metronidazole with topical clindamycin and is delivered discreetly to your door. It’s an empowering way to take action together for better vaginal health.
This product must be purchased by the intended patient assigned male at birth. You will confirm eligibility during checkout.
What's Included
How can Male Partner BV Treatment help?
Eligibility
Get advanced insights into symptoms, fertility, and other health outcomes

Delivered discreetly. Backed by science.
Backed by the latest research showing male partner treatment can reduce BV recurrence.
Empowers partners to break the cycle of BV together
Discreetly delivered to your door. No in-person visits required.
A two-part antibiotic regimen that targets BV bacteria in men

Metronidazole (500mg)
Oral antibiotic

Clindamycin (2%)
Topical antibiotic cream
Backed by science & designed by OB-GYNs
From The Research
reduction in BV recurrence in female partners when male partners were treated, too (Vodstrcil et al 2024).
Providers and patients choose Evvy
FAQ’s for Male Partner BV Treatment
For more, visit our Help Center
Do men need to be treated for BV?
What antibiotics are used for Male Partner BV Treatment?
Can I get Male Partner BV Treatment online without an in‑person doctor visit?
How long does Male Partner BV Treatment take?
Can male BV bacteria come back after treatment?
What are the side effects of metronidazole in Male Partner BV Treatment?
What are the side effects of clindamycin for male BV?
Can I start treatment before my partner is treated?
How discreet is the packaging and billing?








.avif)

.avif)
.avif)






